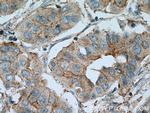
PAGE3 Antibody in Immunohistochemistry (Paraffin) (IHC (P))

Search
Proteintech
PAGE3 Polyclonal Antibody
{{$productOrderCtrl.translations['antibody.pdp.commerceCard.promotion.promotions']}}
{{$productOrderCtrl.translations['antibody.pdp.commerceCard.promotion.viewpromo']}}
{{$productOrderCtrl.translations['antibody.pdp.commerceCard.promotion.promocode']}}: {{promo.promoCode}} {{promo.promoTitle}} {{promo.promoDescription}}. {{$productOrderCtrl.translations['antibody.pdp.commerceCard.promotion.learnmore']}}
产品信息
24598-1-AP
种属反应
宿主/亚型
分类
类型
抗原
偶联物
形式
浓度
规格
纯化类型
保存液
内含物
保存条件
运输条件
产品详细信息
Immunogen sequence: MSGHQRTRS RSRERRDDQD SNHPVGAVVA QELPSDDQLQ QEEPPIESQD YTPGQERDEG ALDFQVLGLA AYLWELTRSK TGGERGDGPN VKGEFLPNLE PVKIPEAGEG QPSV (1-113 aa encoded by BC140001)
靶标信息
PAGE-3 (prostate-associated gene 3 protein), also known as GAGED1 (putative G antigen family Dmember 1), is a 113 amino acid protein that belongsto the GAGE family. The gene that encodes PAGE-3 consists of approximately 6,432 bases andmapsto human chromosome Xp11.21. Chromosome X consists of about 153million base pairs and nearly 1,000 genes. The combination of a X and Y chromosome lead to normal male development while two copies of X lead to normal female development. There are a number ofconditionsrelated to an unusual number and combination ofsexchromosomes being inherited, including Turner's syndrome, Klinefelter'ssyndrome and Triple X syndrome. Color blindness, hemophilia, and Duchennemuscular dystrophy arewellknown X chromosome-linked conditionswhich affectmalesmore frequently as males carry a single X chromosome.
仅用于科研。不用于诊断过程。未经明确授权不得转售。
篇参考文献 (0)
生物信息学
蛋白别名: G antigen family D member 1; G antigen, family D, 1; P antigen family member 3; P antigen family, member 3 (prostate associated); PAGE-3; Prostate-associated gene 3 protein
基因别名: CT16.6; GAGED1; PAGE-3; PAGE3
UniProt ID: (Human) Q5JUK9
Entrez Gene ID: (Human) 139793